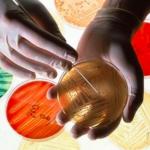

In a lively exchange with Lars Larson, we dove headfirst into the realm of groundbreaking medical advancements, touching on the pressing issue of antibiotic resistance.
antibiotic research
This is both the end and the beginning of an era. I started writing a book, Antibiotics – The Perfect Storm, in 2009 (it was published in 2010). I began writing the blog at the same time.
... since the vast majority of products in the antibiotic pipeline – from early discovery through late-stage clinical development – come from biotech.
To all those who are skeptical because they worry that a government-sponsored investment in the broken antibiotic marketplace is a give-away to the pharmaceutical industry, I have one word for you – covid!
In December, BARDA (the Biomedical Advanced Research and Development Authority, which is part of HHS)
I recently had a chat with Rick Bright. Rick is the Director, Biomedical Advanced Research and Development Authority (BARDA), Deputy Assistant Secretary in the Office of the Assistant Secretary for Preparedness and Response (ASPR), U.